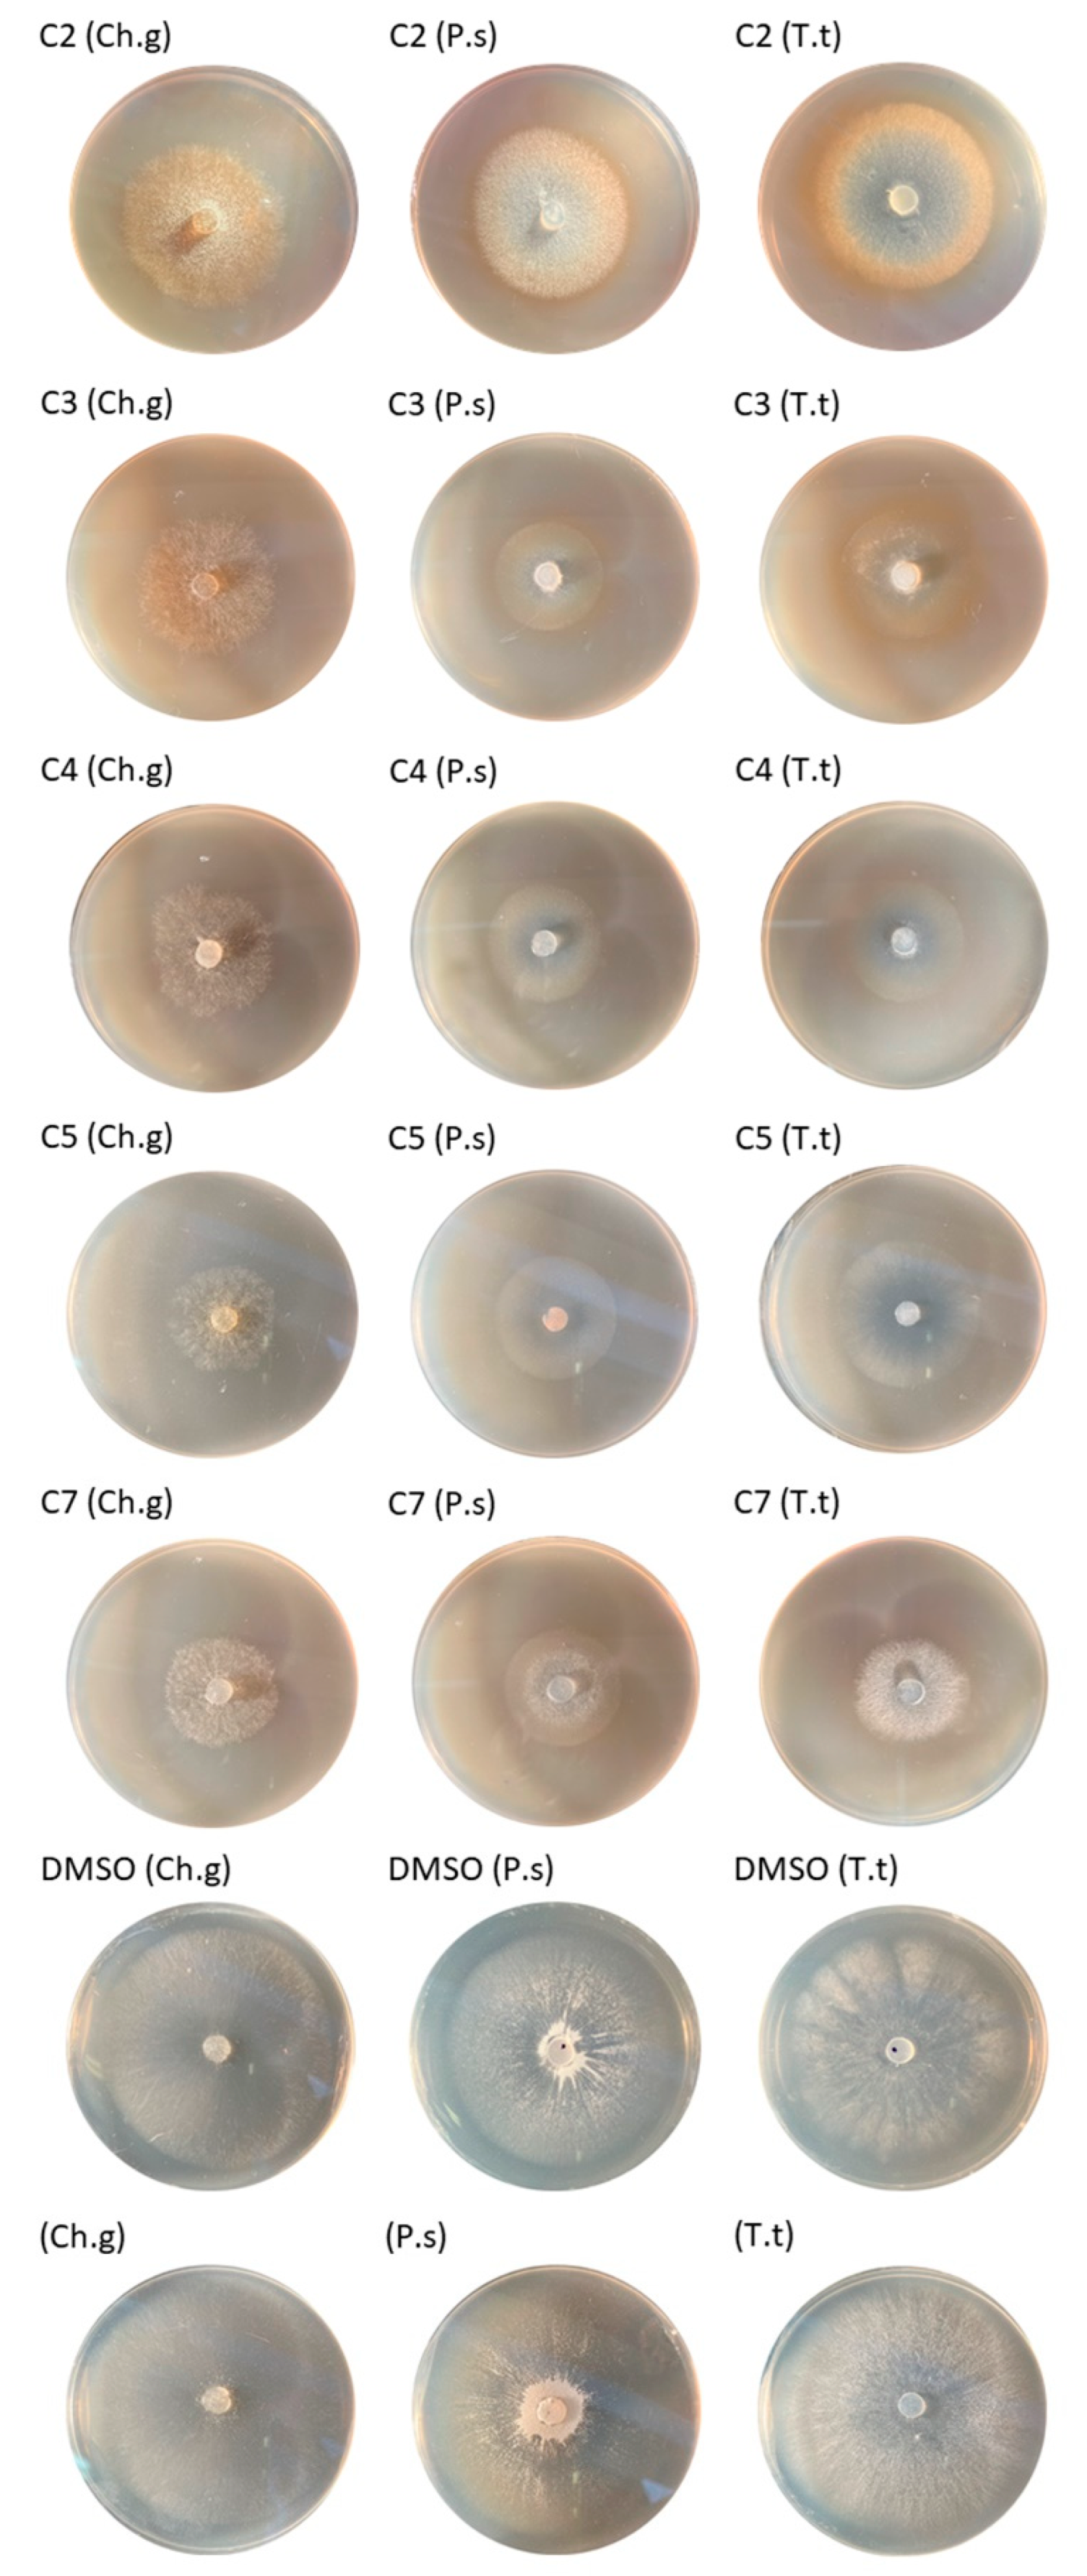
Coatings 14 00237 g002 Coatings 14 00237 g002

Promising Antifungal Activity of Cedrela fissilis Wood Extractives as Natural Biocides against Xylophagous Fungi for Wood Artwork of Cultural Heritage
Abstract
1. Introduction
2. Materials and Methods
2.1. Wood and Fungus Strains
2.2. Wood Extraction and Characterization of Extractives
2.2.1. Analysis by Thin Layer Chromatography (TLC)
2.2.2. Fourier-Transform Infrared Spectroscopy (FTIR)
2.3. Antifungal Activity
Statistical Analysis
3. Results and Discussion
3.1. Wood Extraction and Characterization of Extractives
3.2. Antifungal Activity
3.3. Statistical Analysis
4. Conclusions
Author Contributions
Funding
Institutional Review Board Statement
Informed Consent Statement
Data Availability Statement
Acknowledgments
Conflicts of Interest
References
- Blanchette, R.A. A review of microbial deterioration found in archaeological wood from different environments. Int. Biodeterior. Biodegrad. 2000, 90, 93–98. [Google Scholar] [CrossRef]
- Ciferri, O. The role of microorganisms in the degradation of cultural heritage. Stud. Conserv. 2002, 47, 35–45. [Google Scholar] [CrossRef]
- Strzelczyk, A.B. Observations on aesthetic and structural changes induced in Polish historic objects by microorganisms. Int. Biodeterior. Biodegrad. 2004, 53, 151–156. [Google Scholar] [CrossRef]
- Pournou, A. Biodeterioration of Wooden Cultural Heritage: Organisms and Decay Mechanisms in Aquatic and Terrestrial Ecosystems; Springer: Cham, Swizerland, 2020; 538p. [Google Scholar] [CrossRef]
- Fernández Fueyo, E.; Ruiz Dueñas, F.J.; López Lucendo, M.F.; Pérez Boada, M.; Rencoret, J.; Gutierrez, A.; Pisabarro, A.G.; Ramirez, L.; Martinez, A.T. A secretomic view of woody and nonwoody lignocellulose degradation by Pleurotus ostreatus. Biotechnol. Biofuels 2016, 9, 49. [Google Scholar] [CrossRef] [PubMed]
- Naidu, Y.; Siddiqui, Y.; Rafii, M.Y.; Saud, H.M.; Idris, A.S. Investigating the effect of white-rot hymenomycetes biodegradation on basal stem rot infected oil palm wood blocks: Biochemical and anatomical characterization. Ind. Crops Prod. 2017, 108, 872–882. [Google Scholar] [CrossRef]
- Levin, L.N.; Castro, M.A. Anatomical study of the decay caused by the white-rot fungus Trametes trogii (Aphyllophorales) in wood of Salix and Populus. IAWA J. 1998, 19, 169–180. [Google Scholar] [CrossRef]
- Levin, L.; Viale, A.; Forchiassin, A. Degradation of organic pollutants by the white rot basidiomycete Trametes trogii. Int. Biodeterior. Biodegrad. 2003, 52, 1–5. [Google Scholar] [CrossRef]
- Luna, M.; Murace, M.; Keil, G.; Otaño, M. Patterns of decay caused by Pycnoporus sanguineus and Ganoderma lucidum (Aphyllophorales) in poplar wood. IAWA J. 2004, 25, 425–433. [Google Scholar] [CrossRef]
- Nilsson, T. Studies on wood degradation and cellulolytic activity of microfungi. Stud. For. Suec. 1973, 104, 1–39. [Google Scholar]
- Eaton, R.A.; Hale, M.D.C. Wood: Decay, Pests and Protection; Chapman & Hall: London, UK, 1993. [Google Scholar]
- Wozniak, M. Antifungal agents in wood protection. A review. Molecules 2022, 27, 6392. [Google Scholar] [CrossRef]
- Onuorah, E.O. The wood preservative potentials of heartwood extracts of Milicia excela and Erthrophleum suaveolens. Bioresour. Technol. 2000, 75, 171–173. [Google Scholar] [CrossRef]
- Mbakidi-Ngouaby, H.; Pinault, E.; Gloaguen, V.; Costa, G.; Sol, V.; Millot, M.; Mambu, L. Profiling and seasonal variation of chemical constituents from Pseudotsuga menziesii wood. Ind. Crops Prod. 2018, 117, 34–49. [Google Scholar] [CrossRef]
- Singh, T.; Singh, A.P. A review on natural products as wood protectant. Wood Sci. Technol. 2012, 46, 851–870. [Google Scholar] [CrossRef]
- Lagrouh, F.; Dakka, N.; Bakri, Y. The antifungal activity of Moroccan plants and the mechanism of action of secondary metabolites from plants. J. Mycol. Med. 2017, 27, 303–311. [Google Scholar] [CrossRef] [PubMed]
- Brocco, V.F.; Paes, J.B.; Costa, L.G.; da Brazolin, S.; Arantes, M.D.C. Potential of teak heartwood extracts as a natural wood preservative. J. Clean. Prod. 2017, 142, 2093–2099. [Google Scholar] [CrossRef]
- Kadir, R.; Hale, M. Biocidal potential of the extractives of four Malaysian timbers against subterranean termites and wood decay fungi. Eur. J. Wood Prod. 2019, 77, 147–155. [Google Scholar] [CrossRef]
- Broda, M. Natural Compounds for Wood Protection against Fungi. A review. Molecules 2020, 25, 3538. [Google Scholar] [CrossRef]
- Eller, F.J.; Kirker, G.T.; Mankowski, M.E.; Hay, W.T.; Palmquist, D.E. Effect of burgundy solid extracted from Eastern Red Cedar heartwood on subterranean termites and Wood-decay fungi. Ind. Crops Prod. 2020, 144, 112023. [Google Scholar] [CrossRef]
- Wu, J.F.; Zhuang, X.F.; Yuan, H.M.; Li, Q.; Wang, W.; Li, J.Q.; Lin, J.G. Antifungal ability, and decay resistance of Fokienia hodginsii heartwood extract and its inhibitory effect on Gloeophyllum trabeum. BioResources 2019, 15, 2784–2799. [Google Scholar] [CrossRef]
- Santos, M.B.; Sillero, L.; Gatto, D.A.; Labidi, J. Bioactive molecules in wood extractives: Methods of extraction and separation, a review. Ind. Crops Prod. 2022, 186, 115231. [Google Scholar] [CrossRef]
- Rowell, R.M.; Pettersen, R.; Tshabalala, M.A. Cell Wall Chemistry. In Handbook of Wood Chemistry and Wood Composites, 2nd ed.; Roger, M., Ed.; Rowell CRC Press: Boca Raton, FL, USA, 2012; pp. 34–70. [Google Scholar]
- Doussot, F.; De Jéso, B.; Quideau, S.; Pardon, P. Extractives content in cooperage oak wood during natural seasoning and toasting; influence of tree species, geographic location, and single-tree effects. J. Agric. Food Chem. 2002, 50, 5955–5961. [Google Scholar] [CrossRef]
- Kebbi Benkeder, Z.; Colin, F.; Dumarçay, S.; Gérardin, P. Quantification and characterization of knotwood extractives of 12 European softwood and hardwood species. Ann. For. Sci. 2014, 72, 277–284. [Google Scholar] [CrossRef]
- Prida, A.; Puech, J.L. Influence of geographical origin and botanical species on the content of extractives in American, French, and East European oak woods. J. Agric. Food Chem. 2006, 21, 8115–8126. [Google Scholar] [CrossRef]
- Taylor, A.M.; Gartner, B.L.; Morrell, J.J. Heartwood formation and natural durability. A review. Wood Fiber Sci. 2002, 34, 587–611. [Google Scholar]
- Kilpeläinen, A.; Peltola, H.; Ryyppö, A. Scots pine responses to elevated temperature and carbon dioxide concentration: Growth and wood properties. Tree Physiol. 2005, 25, 75–83. [Google Scholar] [CrossRef]
- Achim, A.; Blanchet, P.; Schmitt, U.; Bouffard, J.F. Characterization of extractives in tree biomass and by-products of Plywood and Saw Mills from Finnish birch in different climatic regions for value-added chemical products. In Proceedings of the ISCHP 15: International Scientific Conference on Hardwood Processing Proceedings, Québec City, QC, Canada, 15–17 September 2015. [Google Scholar]
- Routa, J.; Brännström, H.; Anttila, P.; Mäkinen, M.; Jänis, J.; Asikainen, A. Wood extractives of Finnish pine, spruce and birch–availability and optimal sources of compounds: A literature review. Nat. Resour. Bioecon. Stud. 2017, 73, 55. [Google Scholar]
- Challinor, J.M. Characterization of wood extractives by pyrolysis-gas chromatography/mass spectrometry of quaternary ammonium hydroxide extracts. J. Anal. Appl. Pyrolysis 1996, 37, 1–13. [Google Scholar] [CrossRef]
- Royer, M.; Herbette, G.; Eparvier, V.; Beauchêne, J.; Thibaut, B.; Stien, D. Secondary metabolites of Bagassa guianensis Aubl. wood: A study of the chemotaxonomy of the Moraceae family. Phytochem 2010, 71, 1708–1713. [Google Scholar] [CrossRef][Green Version]
- Yin, X.; Huang, A.; Zhang, S.; Liu, R.; Ma, F. Identification of three Dalbergia species based on differences in extractive components. Molecules 2018, 23, 2163. [Google Scholar] [CrossRef]
- Felhofer, M.; Prats-Mateu, B.; Bock, P.; Gierlinger, N. Antifungal stilbene impregnation: Transport and distribution on the micron-level. Tree Physiol. 2018, 38, 1526–1537. [Google Scholar] [CrossRef] [PubMed]
- Valette, N.; Perrot, T.; Sormani, R.; Gelhaye, E.; Morel Rouhier, M. Antifungal activities of wood extractives. Fungal Biol. Rev. 2017, 31, 113–123. [Google Scholar] [CrossRef]
- Anouhe, J.B.S.; Niamké, F.B.; Faustin, M. The role of extractives in the natural durability of the heartwood of Dicorynia guianensis Amsh: New insights in antioxydant and antifungal properties. Ann. For. Sci. 2018, 75, 15. [Google Scholar] [CrossRef]
- Ateş, S.; Gür, M. Chemical contents and antifungal activity of some durable wood extractives vs. Pleurotus ostreatus. BioResources 2015, 10, 2433–2443. [Google Scholar] [CrossRef][Green Version]
- Wang, J.; Li, J.; Li, S.; Freitag, C.; Morrell, J.J. Antifungal activities of Cunninghamia lanceolata heartwood extractives. BioResources 2011, 6, 606–614. [Google Scholar] [CrossRef]
- de Andrade, J.H.C.; Rodrigues, J.; Benites, A.; Benites, C.; Acosta, A.; Benites, M.; Benites, C.; Gomes, I.; da Silva, J.V.; Antunes, E.; et al. Notes on current Mbyá-Guarani medicinal plant exchanges in southern Brazil. J. Ethnobiol. Ethnomed. 2021, 17, 38. [Google Scholar] [CrossRef]
- Nogueira, T.S.R.; Passos, M.S.; Nascimento, L.P.S.; Arantes, M.B.S.; Monteiro, N.O.; Bueno, S.I.D.S.; de Carvalho Junior, A.; Azevedo, O.A.; Terra, W.D.S.; Vieira, M.G.C.; et al. Chemical compounds and biologic activities: A Review of Cedrela genus. Molecules 2020, 25, 5401. [Google Scholar] [CrossRef]
- Ambrozin, A.R.; Leite, A.C.; Bueno, F.C.; Vieira, P.C.; Fernandes, J.B.; Bueno, O.C.; Bacci, M., Jr. Limonoids from andiroba oil and Cedrela fissilis and their insecticidal activity. J. Braz. Chem. Soc. 2006, 17, 542–547. [Google Scholar] [CrossRef]
- Leite, A.C.; Ambrozin, A.R.P.; Fernandes, J.B.; Vieira, P.C.; Da Silva, M.F.D.G.F.; De Albuquerque, S. Trypanocidal activity of limonoids and triterpenes from Cedrela fissilis. Planta Med. 2008, 74, 1795–1799. [Google Scholar] [CrossRef]
- Bueno, F.C.; Godoy, M.P.; Leite, A.C.; Bueno, O.C.; Pagnocca, F.C.; Fernandes, J.B.; Hebling, M.J.A.; Bacci, M.; Vieira, P.C.; Silva, M.F.G.F. Toxicity of Cedrela fissilis to Atta sexdens rubropilosa (Hymenoptera: Formicidae) and its symbiotic fungus. Sociobiology 2005, 45, 389–399. [Google Scholar]
- Fazio, A.T.; Papinutti, L.; Gómez, A.; Parera, S.D.; Rodríguez Romero, A.; Siracusano, G.; Maier, M.S. Fungal deterioration of a Jesuit South American polychrome wood sculpture. Int. Biodeterior. Biodegrad. 2010, 64, 694–701. [Google Scholar] [CrossRef]
- Balouiri, M.; Sadiki, M.; Koraichi Ibnsouda, S. Methods for in vitro evaluating antimicrobial activity: A review. J. Pharm. Anal. 2016, 6, 71–79. [Google Scholar] [CrossRef] [PubMed]
- Posit Team. RStudio: Integrated Development Environment for R; Posit Software; PBC: Boston, MA, USA, 2023; Available online: http://www.posit.co/ (accessed on 25 December 2023).
- R Core Team. R: A Language and Environment for Statistical Computing; R Foundation for Statistical Computing: Vienna, Austria, 2023; Available online: https://www.R-project.org/ (accessed on 25 December 2023).
- Campos, A.M.; Oliveira, F.S.; Machado, M.I.L.; Matos, F.J.A.; Braz-Filho, R. Triterpenes from Cedrela odorata. Phytochem 1991, 30, 1225–1229. [Google Scholar] [CrossRef]
- Segura, R.; Calderón, J.; Toscano, R.; Gutiérrez, A.; Mata, R. Cedrelanolide I, A new limonoid from Cedrela salvadorenis. Tetrahedron Lett. 1994, 35, 3427–3440. [Google Scholar] [CrossRef]
- Céspedes, C.L.; Calderón, J.S.; Gomez-Garibay, F.; Segura, R.; King-Diaz, B.; Lotina-Hennsen, B. Phytogrowth properties of limonoids isolated from Cedrela ciliolata. J. Chem. Ecol. 1999, 25, 2665–2676. [Google Scholar] [CrossRef]
- Lehr, M.; Miltner, M.; Friedl, A. Removal of wood extractives as pulp (pre-)treatment: A technological review. SN Appl. Sci. 2021, 3, 886. [Google Scholar] [CrossRef]
- Björklund, J.; Marianne; Nilvebrant, N.O. Wood Chemistry and Wood Biotechnology; De Gruyter: Berlin, Germany, 2009; Volume 1, pp. 147–172. [Google Scholar]
- Lv, H.; Wang, Y.; Qu, M.; Zhang, Y.; Song, Z.; Su, X.; Xu, B. Anti-fungal Activity of Dalbergia retusa Extract on Gloeophyllum trabeum. Front. Plant Sci. 2022, 13, 906041. [Google Scholar] [CrossRef] [PubMed]
- Ribeiro, S.B.; Pagnocca, F.C.; Victor, S.R.; Bueno, O.C.; Hebling, M.G.; Bacci, M., Jr.; Silva, O.A.; Fernandes, J.B.; Vieira, P.C.; Silva, M.F.G.F. Activity of sesame leaf extracts Against the symbiotic fungus of Atta sexdens L. An. Soc. Entomológica Bras. 1998, 27, 421–426. [Google Scholar] [CrossRef]
- Moore, R.K.; Smaglick, J.; Arellano-ruiz, E.; Leitch, M.; Mann, D. The effect of polarity of extractives on the durability of wood. In Proceedings of the 18th ISWFPC (International Symposium on Wood, Fiber, and Pulping Chemistry), Vienna, Austria, 9–11 September 2015. [Google Scholar]
- Vek, V.; Oven, P.; Humar, M. Phenolic extractives of wound-associated wood of beech and their fungicidal effect. Int. Biodeterior. Biodegrad. 2013, 77, 91–97. [Google Scholar] [CrossRef]
- Tchinda, J.B.S.; Ndikontar, M.K.; Founda Belinga, A.D.; Mounguengui, S.; Njankouo, J.M.; Durmaçay, S.; Geradin, P. Inhibition of fungi with wood extractives and natural durability of five Cameroonian wood species. Ind. Crops Prod. 2018, 123, 183–191. [Google Scholar] [CrossRef]
- Candelier, K.; Thévenon, M.F.; Collet, R.; Gérardin, P.; Dumarçay, S. Antifungal and antitermite activity of extractives compunds from thermally modified ash woods. Maderas. Cienc. Tecnol. 2020, 22, 223–240. [Google Scholar] [CrossRef]
- Stirling, R.; Daniels, C.R.; Clark, J.E.; Morris, P.I. Methods for Determining the Role of Extractives in the Natural Durability of Western Red Cedar; IRG: Stockholm, Sweden, 2007. [Google Scholar]
- Tascioglu, C.; Yalcin, M.; Sen, S.; Akcay, C. Antifungal properties of some plant extracts used as wood preservatives. Int. Biodeterior. Biodegrad. 2013, 85, 23–28. [Google Scholar] [CrossRef]
- Roux, D.G.; Ferreira, D.; Botha, J.J. Structural considerations in predicting the utilization of tannins. J. Agric. Food Chem. 1980, 28, 216–222. [Google Scholar] [CrossRef]
- Roux, D.G. Reflections on the chemistry and affinities of the major commercial condensed tannins in the context of their industrial use. In Plant Polyphenols; Basic Life Sciences; Springer: Boston, MA, USA, 1992. [Google Scholar] [CrossRef]
- Kawamura, F.; Mahamud, A.; Sulaiman, O.; Hashim, R. Antifungal activities of extracts from heartwood, sapwood and bark of 11 malaysian timbers against Gloeophyllum trabeum and Pycnoporus sanguineus. J. Trop. For. Sci. 2010, 22, 170–174. [Google Scholar]
- Anis, Z.; Sulaiman, O.; Hashim, R.; Mehdi, S.H.; Ghali, R.M. Radical scavenging activity, total phenol content and antifungal activity of Cinnamomum iners wood. Iran. J. Energy Environ. 2012, 3, 74–78. [Google Scholar] [CrossRef]
- Bento, T.S.; Torres, L.M.B.; Fialho, M.B.; Bononi, V.L.R. Growth inhibition and antioxidative response of wood decay fungi exposed to plant extracts of Casearia species. Lett. Appl. Microbiol. 2013, 58, 79–86. [Google Scholar] [CrossRef] [PubMed]
- Harmen, M.S.; Ramle, S.F.M. Antifungal activities of methanol extract from Syzygium chlorantha and Hopea spp. against Pycnoporus sanguineus. J. Trop. Resour. Sustain. 2016, 4, 88–94. [Google Scholar] [CrossRef]
- Souza Reis, A.R.; Gomes Loch, A.; da Costa Oliveira Moreir, S.M.; da Costa Gondim, M.; Rogério da Silva, M.; Soares Bilhalva dos Santos, P. Natural resistance of wood from three forest species exposed to Pycnoporus sanguineus xylophagous fungus. Adv. For. Sci. 2019, 6, 839–842. [Google Scholar] [CrossRef]
- Salem, M.Z.; Zidan, Y.E.; El Hadidi, N.M.; Mansour, M.M.; Elgat, W.A.A. Evaluation of usage three natural extracts applied to three commercial wood species against five common molds. Int. Biodeter. Biodegr. 2016, 110, 206–226. [Google Scholar] [CrossRef]
- Cirone, M.; Figoli, A.; Galiano, F.; La Russa, M.F.; Macchia, A.; Mancuso, R.; Ricca, M.; Rovella, N.; Taverniti, M.; Ruffolo, S.A. Innovative methodologies for the conservation of cultural heritage against biodeterioration: A review. Coatings 2023, 13, 1986. [Google Scholar] [CrossRef]

| Extract Code | Extract Recovered (mg) | % Extract Recovered |
|---|---|---|
| C1 | 53.5 | 0.5 |
| C2 | 71.9 | 0.7 |
| C3 | 250.2 | 2.5 |
| C4 | 184.4 | 1.8 |
| C5 | 100.2 | 1 |
| C6 | 28.6 | 0.3 |
| C7 | 74.8 | 0.7 |
| Inhibition (%) | |||
|---|---|---|---|
| Extract Code | Ch. globosum | P. sanguineus | T. trogii |
| C2 | 29.57 ± 1.56 | 27.84 ± 2.23 | 25.12 ± 2.93 |
| C3 | 16.20 ± 3.95 | 30.11 ± 1.66 | 24.34 ± 2.00 |
| C4 | 29.66 ± 2.29 | 32.28 ± 1.08 | 31.62 ± 1.93 |
| C5 | 52.31 ± 1.73 | 42.92 ± 1.56 | 33.77 ± 2.76 |
| C7 | 35.22 ± 2.48 | 31.62 ± 0.80 | 32.61 ± 1.60 |
Disclaimer/Publisher’s Note: The statements, opinions and data contained in all publications are solely those of the individual author(s) and contributor(s) and not of MDPI and/or the editor(s). MDPI and/or the editor(s) disclaim responsibility for any injury to people or property resulting from any ideas, methods, instructions or products referred to in the content. |
© 2024 by the authors. Licensee MDPI, Basel, Switzerland. This article is an open access article distributed under the terms and conditions of the Creative Commons Attribution (CC BY) license (https://creativecommons.org/licenses/by/4.0/).
Share and Cite
Vovchuk, C.S.; González Garello, T.; Careaga, V.P.; Fazio, A.T. Promising Antifungal Activity of Cedrela fissilis Wood Extractives as Natural Biocides against Xylophagous Fungi for Wood Artwork of Cultural Heritage. Coatings 2024, 14, 237. https://doi.org/10.3390/coatings14020237
Vovchuk CS, González Garello T, Careaga VP, Fazio AT. Promising Antifungal Activity of Cedrela fissilis Wood Extractives as Natural Biocides against Xylophagous Fungi for Wood Artwork of Cultural Heritage. Coatings. 2024; 14(2):237. https://doi.org/10.3390/coatings14020237
Chicago/Turabian StyleVovchuk, Camila Sofía, Tomás González Garello, Valeria Pilar Careaga, and Alejandra Teresa Fazio. 2024. "Promising Antifungal Activity of Cedrela fissilis Wood Extractives as Natural Biocides against Xylophagous Fungi for Wood Artwork of Cultural Heritage" Coatings 14, no. 2: 237. https://doi.org/10.3390/coatings14020237
APA StyleVovchuk, C. S., González Garello, T., Careaga, V. P., & Fazio, A. T. (2024). Promising Antifungal Activity of Cedrela fissilis Wood Extractives as Natural Biocides against Xylophagous Fungi for Wood Artwork of Cultural Heritage. Coatings, 14(2), 237. https://doi.org/10.3390/coatings14020237

